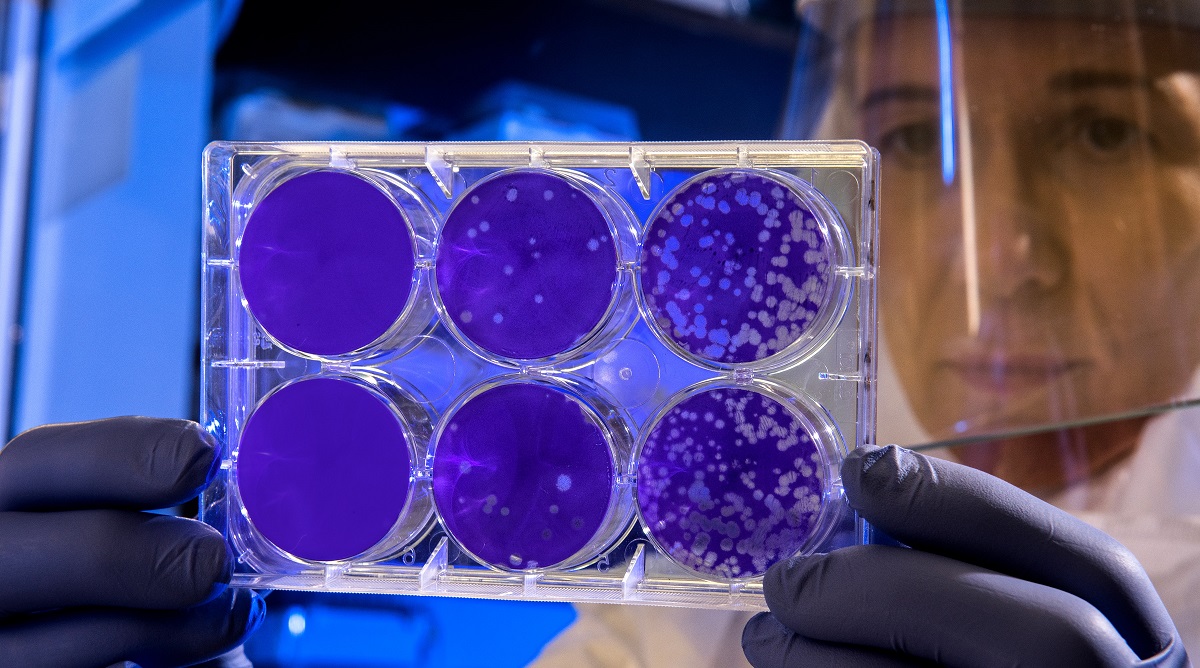
Εταιρεία ανέπτυξε τεστ-εξπρές που επιτρέπει την ανίχνευση του κορωνοϊού Covid-19 σε λιγότερο από δύο ώρες

Δεν μπορεί να προβλεφθεί η «πορεία» του κορωνοϊού, τόνισε ο επικεφαλής του ΠΟΥ
Είναι ακόμη «πάρα πολύ νωρίς» να προβλέψουμε το τέλος της επιδημίας που προκάλεσε ο νέος κορωνοϊός, που εμφανίστηκε στην Κίνα, αναφέρει ο Παγκόσμιος Οργανισμός Υγείας. «Πιστεύω ότι σήμερα είναι πάρα πολύ νωρίς να επιχειρήσουμε να προβλέψουμε την αρχή, τη μέση ή το τέλος αυτής της επιδημίας» δήλωσε ενώπιον δημοσιογράφων ο Μάικλ Ράιαν, ο επικεφαλής του τμήματος [...]